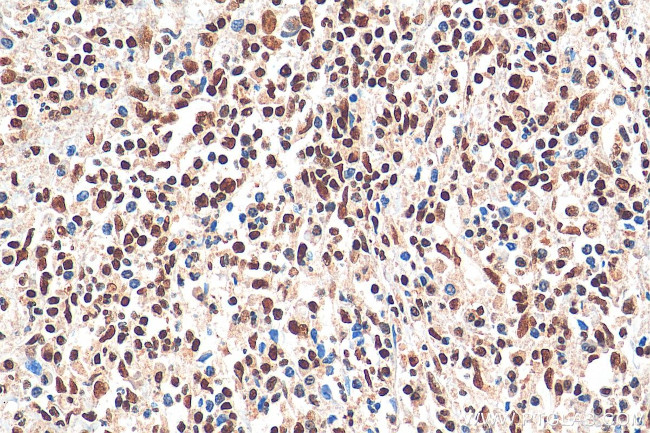
CREB1 Antibody in Immunohistochemistry (Paraffin) (IHC (P))

Search
Proteintech
CREB1 Monoclonal Antibody (1E11C1)
{{$productOrderCtrl.translations['antibody.pdp.commerceCard.promotion.promotions']}}
{{$productOrderCtrl.translations['antibody.pdp.commerceCard.promotion.viewpromo']}}
{{$productOrderCtrl.translations['antibody.pdp.commerceCard.promotion.promocode']}}: {{promo.promoCode}} {{promo.promoTitle}} {{promo.promoDescription}}. {{$productOrderCtrl.translations['antibody.pdp.commerceCard.promotion.learnmore']}}
产品信息
67927-1-IG150UL
种属反应
宿主/亚型
分类
类型
克隆号
偶联物
形式
浓度
规格
纯化类型
保存液
内含物
保存条件
运输条件
靶标信息
CREB (Cyclic AMP response element binding protein) is a 43 kDa basic/leucine zipper transcription factor that binds the cyclic AMP response element (CRE) and activates transcription in response to a variety of extracellular signals including neurotransmitters, hormones, membrane depolarization, and growth and neurotrophic factors. Activation of CREB is dependent upon the phosphorylation of serine 133. Phosphorylation of CREB occurs via p44/42 MAP kinase and p90RSK, and via p38 MAP kinase and MSK1. Although CREB will bind DNA independent of its phosphorylation state, only the phosphorylated form is competent as a transcription factor. CREB binding protein (CBP), a transcriptional coactivator that directly interacts with CREB, binds to CREB in the region of serine 133. CREB is involved in different cellular processes including the synchronization of circadian rhythmicity, differentiation of adipose cells, and learning and memory. In humans, the gene is located on the q arm of chromosome 2. Diseases associated with CREB dysfunction include Alzheimer's Disease, histiocytoma and soft tissue melanoma.
仅用于科研。不用于诊断过程。未经明确授权不得转售。
篇参考文献 (0)
生物信息学
蛋白别名: active transcription factor CREB; active transcription factor CREB-A; active transcription factor CREB-B; cAMP response element binding protein 1; cAMP-response element-binding protein-1; cAMP-responsive element-binding protein 1; CREB-1; CREB1; cyclic adenosine 3',5'-monophosphate response element binding protein; cyclic adenosine 3',5'-monophosphate response element-binding protein CREB; cyclic AMP response element-binding protein-1 alpha isoform; Cyclic AMP-responsive element-binding protein 1; delta CREB; htCREB; MGC9284; OTTHUMP00000206661; OTTHUMP00000206662; OTTHUMP00000206667; transactivator protein; unnamed protein product; Y protein
基因别名: 2310001E10Rik; 3526402H21Rik; AV083133; CREB; CREB-1; CREB1
UniProt ID: (Human) P16220, (Mouse) Q01147, (Rat) P15337
Entrez Gene ID: (Human) 1385, (Mouse) 12912, (Rat) 81646